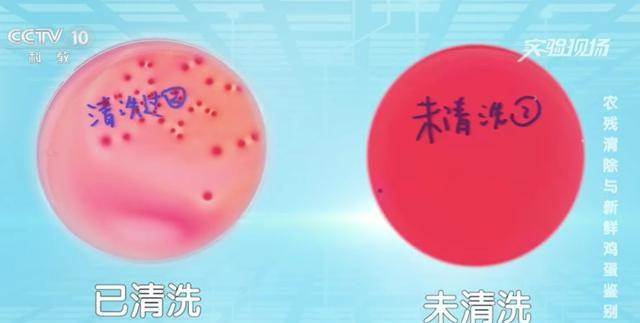

瀋陽那一家三口,只是想把雞蛋洗得乾淨點,結果半夜排隊掛急診。

醫生一句話把在場的人都點醒:蛋殼上那層肉眼看不見的保護膜,比洗碗巾金貴得多,水一衝,細菌就像拿到通行證,24小時就能在蛋清裡開派對。
聽起來像小題大做,可中國農大剛出的資料擺在那兒——25℃室溫下放一天,沙門氏菌翻十倍,數字冷冰冰,卻足夠讓一鍋蛋花湯變成「生化武器」。
所以別再把「雞蛋殼厚」當成天然保險箱,它其實更像紙糊的門,一捅就破。
有人抬槓:老祖宗吃了幾百年常溫蛋,不也活蹦亂跳。
說這話的人忽略了兩個變數:現在的流通時間更長,夏天冷鏈斷點更多。
以前從雞窩到灶臺可能只隔一個院子,如今得先跨省再進超市,蛋在箱子裡悶三天,早不是當年那枚「素顏蛋」。
時間差,就是細菌差。
洗不得,那該怎麼整。
答案其實挺市井:買回直接扔冰箱,4℃以下最安心;盒子別再用紙格,換成帶蓋的硬塑料盒,省得雞蛋吸完生肉味又蹭上剩菜汁;擺的時候大頭朝上,氣室在上,蛋黃就能懸在中間,不貼殼壁,保質期悄悄拉長。
整套動作下來,比刷五個碗還快,卻能把風險直接腰斬。
日本最近整了個「奈米塗層」黑科技,雞蛋出廠前噴一層食品級液體,髒東西沖掉,保護膜卻完好,保鮮期還能再拉長一成五。
好消息是,國內幾家高階超市已經開始試點;壞消息是,價格也跟著上浮。
錢包緊的人,其實只要把「不洗+冷藏+蓋盒」三步做到位,也能達到八九成效果,窮有窮的辦法。
至于存放多久算「過期」,業內有個暗號:30天是紅線,7到14天是黃金口感區。
超過兩週,蛋清開始發稀,煎蛋時邊緣不再圓潤,像洩了氣的游泳圈;一旦蛋黃輕碰就散,趕緊整袋扔,別心疼那幾塊錢,醫藥費夠買半年蛋。

夏天尤其別逞能,高溫會讓細菌坐上火箭,日期得按「對摺」算,冬天30天,夏天就當15天用。
最後挑蛋也有小心機:看生產日期別只看牌子,同樣一盒「本週蛋」比「上週蛋」貴五毛,可細菌基數能差出幾十萬;殼上帶雞糞的,別自我安慰「原生態」,那是最容易窩藏沙門氏菌的「定時炸彈」。
選乾淨、無裂紋、冷鏈櫃裡的,才是真金白銀的「安全款」。
廚房裡最不起眼的一枚蛋,其實天天在跟時間賽跑。
給它一點「冷鏈待遇」,它就能回報一頓安心早餐;省那一步,急診室的吊瓶會替你補交學費。
生活已經夠累了,別讓一口蛋再把人放倒,知識就是免疫力,冰箱就是護身符,把蛋放好,比會煎溏心蛋更見真功夫。
